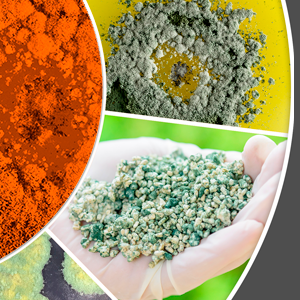
Uso de bioinsumos para el control de plagas

Energias-renovables-y-produccion-sostenible
Requisitos de finalización
Última modificación: jueves, 7 de septiembre de 2023, 17:36


Produzcamos compost
Al finalizar este micromódulo, podrás explicar qué es el compostaje, nombrar los materiales requeridos para hacerlo y distinguir las fases del proceso de descomposición de los materiales. Conocimientos previos: No requeridos - Duración: 25 min
Uso de bioinsumos para el control de plagas
En este micromódulo te presentaremos el uso de los bioinsumos como una alternativa sostenible para el manejo de plagas y enfermedades. Conocimientos previos:
Conocimientos básicos de agricultura - Duración: 40 min

Producción de biogás mediante biodigestores de baja carga
En este micromódulo aprenderás a distinguir qué es un biodigestor, cómo funciona y cuáles son las reacciones bioquímicas que ocurren en su interior.
Conocimientos previos:
Conocimientos básicos de química y biología - Duración: 30 min

Entendiendo la energía del agua
Al finalizar este micromódulo, podrás reconocer la definición de energía hidroeléctrica e identificar los factores que afectan su potencia. Conocimientos previos: Conocimientos básicos de matemáticas - Duración: 30 min

Manejo integrado de las enfermedades en los cultivos
Este micromódulo te permitirá describir los factores que contribuyen al desarrollo de enfermedades en los cultivos y las estrategias para prevenirlas y controlarlas. Conocimientos previos: No requeridos - Duración: 20 min

Manejo integral de una finca sana
Cuando finalices este micromódulo, reconocerás la utilidad de implementar el enfoque finca sana en cada etapa de tu cultivo y podrás medir su impacto en términos de productividad y sostenibilidad. Conocimientos previos: No requeridos - Duración: 45 min


